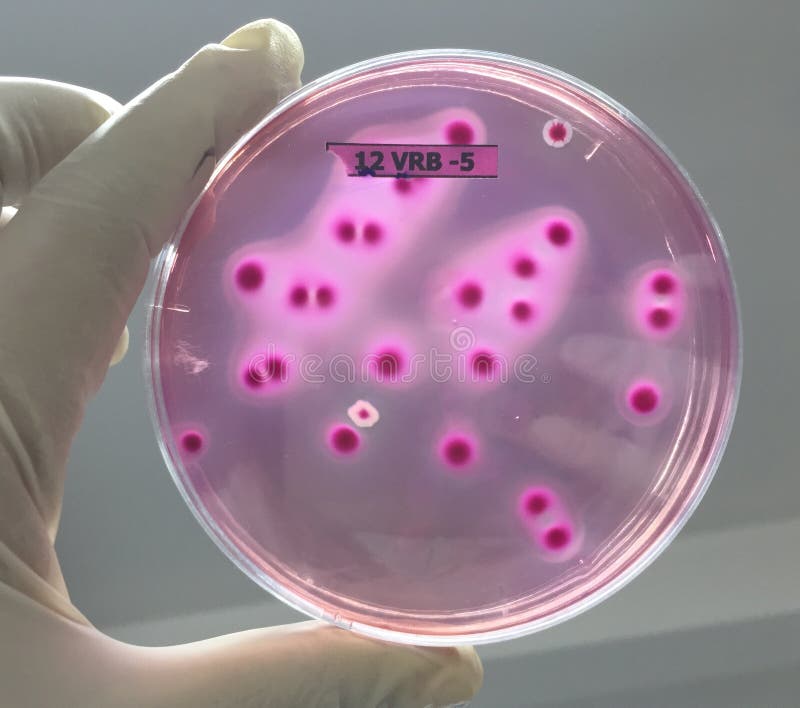

Грам-положительные и грам-отрицательные Escherichia coli: фотогалерея























































:max_bytes(150000):strip_icc()/e.coli_bacteria-596fcbfdb501e800112b7a72.jpg)

Раздел: Другие животные